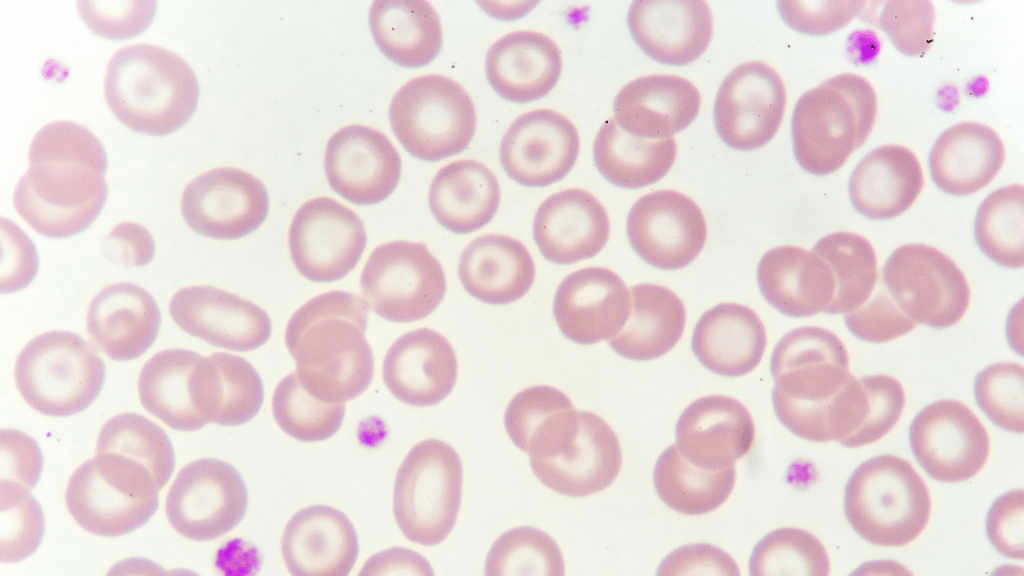

Lupus dapat mempengaruhi berbagai sistem organ, seperti muskuloskeletal, darah, ginjal, neuropsikiatri, kardiovaskular, dan pernapasan. Oleh karena itu, tanda dan gejala yang muncul dapat berbeda-beda pada setiap orang, tergantung organ mana yang terkena.
Tidak semua gejala muncul secara bersamaan. Kadang-kadang, gejala satu dengan yang lain muncul perlahan-lahan, bahkan dengan interval waktu beberapa bulan hingga tahun.
Berikut adalah beberapa gejala yang sering ditemukan pada pasien lupus.
1. Selalu merasa lelah, bahkan dengan istirahat yang cukup

2. Demam tanpa sebab yang jelas

3. Nyeri sendi, dapat disertai pembengkakan sendi

4. Nyeri otot, biasanya terjadi pada area leher, paha, bahu, dan lengan atas

5. Ruam malar, yaitu ruam berbentuk seperti kupu-kupu pada area pipi dan hidung

6. Rambut rontok. Biasanya terdapat area yang mengalami kebotakan akibat rambut rontok.

7. Sensitif terhadap sinar matahari. Pada pasien lupus, paparan sinar matahari dapat memicu ruam, nyeri sendi, atau demam.

8. Sariawan. Biasanya dapat ditemukan pada langit mulut, namun dapat ditemukan juga pada gusi, pipi, dan bibir.

9. Fenomena Raynaud. Jari-jari tangan dan kaki menjadi pucat hingga kebiruan apabila suhu ruangan/cuaca dingin atau stress.

10. Kelainan darah. Biasanya ditemukan hemoglobin yang rendah (anemia), penurunan jumlah sel darah putih (leukositopenia), atau penurunan jumlah trombosit (trombositopenia).
11. Nyeri dada saat menarik napas dalam. Ketika lupus menyerang sistem pernapasan, terjadi peradangan pada selaput paru-paru (pleura) yang menyebabkan nyeri saat menarik napas.

12. Gangguan ginjal. Pasien dapat mengeluhkan penambahan berat badan dan pembengkakan pada kaki akibat overload cairan. Pada pemeriksaan urin dapat ditemukan protein, pada pemeriksaan darah dapat ditemukan penurunan fungsi ginjal.

13. Gangguan memori, kejang, perubahaan mood, hingga halusinasi. Hal ini terjadi akibat gangguan pada sistem neuropsikiatri.

14. Keguguran berulang. Pasien lupus berisiko tinggi mengalami pembekuan darah yang dapat mengganggu aliran darah pada janin, sehingga pasien wanita usia produktif dengan riwayat keguguran berulang perlu dicurigai sebagai lupus.

Bagaimanakah Cara Deteksi Dini Lupus?
Anda dapat melakukan pemeriksaan sederhana di rumah untuk deteksi dini lupus dengan melakukan pemeriksaan Periksa Lupus Sendiri (SALURI). Terdapat 11 poin yang dapat Anda kaji.
- Apakah persendian Anda sering terasa sakit, nyeri atau bengkak lebih dari 3 bulan?
- Apakah jari tangan dan/ jari kaki pucat, kaku atau tidak nyaman di saat dingin?
- Apakah Anda pernah menderita sariawan lebih dari 2 minggu?
- Apakah Anda mengalami kelainan darah seperti: anemia, leukositopenia, atau trombositopenia?
- Pernahkah pada wajah Anda terdapat ruam kemerahan berbentuk kupu-kupu yang sayapnya melintang dari pipi ke pipi?
- Apakah Anda sering demam diatas 38ºC dengan sebab yang tidak jelas?
- Apakah Anda pernah mengalami nyeri dada selama beberapa hari saat menarik nafas?
- Apakah Anda sering merasa sangat lelah dan sangat lemas, bahkah setelah cukup beristirahat?
- Apakah kulit Anda hipersensitif terhadap sinar matahari?
- Apakah terdapat protein pada pemeriksaan urin Anda?
- Pernahkah Anda mengalami serangan kejang?
Apabila Anda menjawab “YA” pada minimal 4 pertanyaan, terdapat kemungkinan Anda menderita lupus. Segera periksakan diri Anda ke dokter, apabila memungkinkan segera konsultasikan kondisi Anda ke dokter spesialis penyakit dalam konsultan Reumatologi.
Referensi:
- Gergianaki I, Bertsias G. Systemic Lupus Erythematosus in Primary Care: An Update and Practical Messages for the General Practitioner. Front Med. 2018;5:161.
- Al-Gahtani S. A Review of Systemic Lupus Erythematosus (SLE): Symptoms, Risk Factors, Treatment, and Health Related Quality of Life Issues. Open Journal of Rheumatology and Autoimmune Diseases. 2021;11(4):115-143.
- Metry AM, Al Salmi I, Al Balushi F, et al. Systemic Lupus Erythematosus: Symptoms and Signs at Initial Presentations. Antiinflamm Antiallergy Agents Med Chem. 2019;18(2):142-150.






Tinggalkan komentar